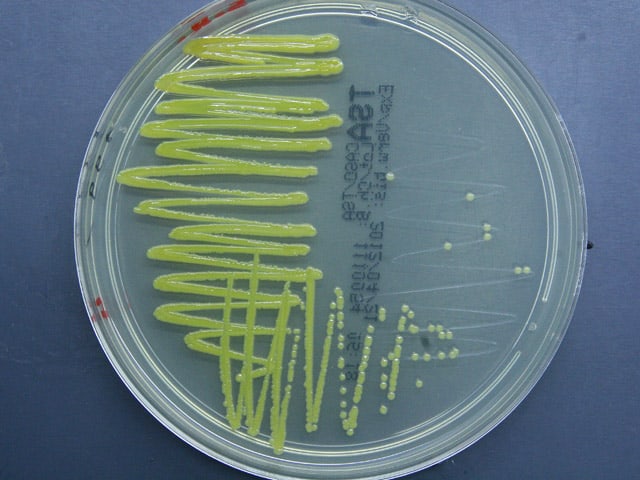

Aquarium Dietzenbach ist ein Zierfischgroßhandel, der seit 1985 seine Fische aus den 16 wichtigsten Herkunftsländern importiert. Den Schwerpunkt legen wir dabei auf Nachzuchten, was allerdings nicht bei allen Arten immer möglich ist. Die Tiere, die noch nicht gezüchtet werden, werden unter den bestehenden Richtlinien des jeweiligen Herkunftslandes tier- und artschutzgerecht gefangen und bei unseren Lieferanten fachgerecht für den Transport vorbereitet. Die Tiere werden bei uns nach ihrer Ankunft sorgfältig eingewöhnt und von Ekto-und Schwächeparasiten befreit. Eine ausreichende Verweilzeit unter optimalen Bedingungen sorgt dafür, dass die Tiere mit einem bestens ausgerüsteten Immunsystem zu unseren Kunden kommen.
Um das zu ermöglichen, steht uns eine technisch moderne Anlage zur Verfügung, die es erlaubt, dass wir ständig einen Tierbestand von ca. 600.000 Tieren unter besten Bedingungen eingewöhnen können.
Aquarium Dietzenbach ist nicht ausschließlich wirtschaftlich orientiert, sondern bei uns werden Aquaristik und Terraristik auch gelebt. Was den meisten bisher verborgen geblieben ist, ist eine Zuchtabteilung für Fische und Garnelen sowie eine Zuchtabteilung für Amphibien und Reptilien, bei der es in naher Zukunft sicherlich einige Überraschungen geben wird.
Bitte beachten Sie, dass Sie NICHT bei uns direkt kaufen können. Wenn Sie Interesse an unseren Tieren haben, wenden Sie sich direkt an Ihren Zoofachhändler. Sie finden unsere Kunden in unserer Website www.aquarium-dietzenbach.de in der Rubrik “Hier gibt es unsere Tiere“.
| Homepage: http://www.aquarium-dietzenbach.deYouTube: http://www.youtube.com/user/AquariumDietzenbach |